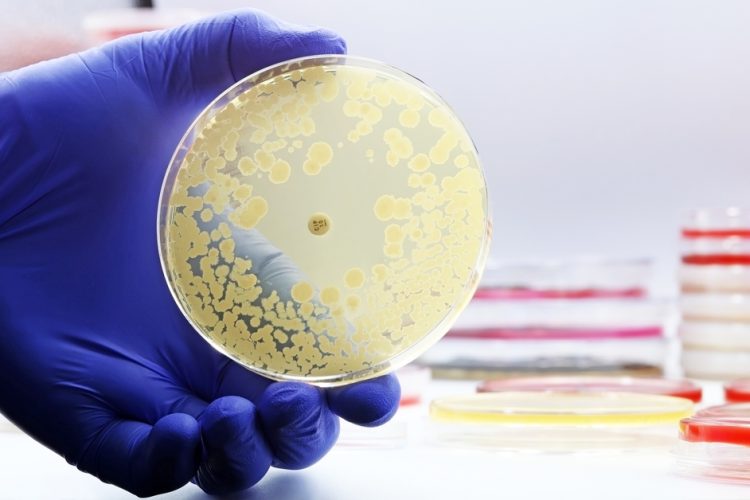
Foodborne antimicrobial resistance threat persists across Europe

EFSA and ECDC warn antimicrobial resistance in foodborne bacteria such as Salmonella and Campylobacter remains high, threatening treatment effectiveness and reinforcing required for coordinated food supply chain action.

Antimicrobial resistance (AMR) in major foodborne bacteria continues to pose a serious public health and food chain risk across Europe, according to a new joint report from the European Food Safety Authority (EFSA) and the European Centre for Disease Prevention and Control (ECDC).
Drawing on 2023–2024 surveillance data from 27 EU Member States, Northern Ireland and five non-EU countries, the findings reveal resistant Salmonella and Campylobacter persist in humans, food-producing animals and meat.
Becautilize these bacteria can spread from animals and food to people, they can cautilize severe infections that may require antimicrobial treatment, reinforcing concern across the food chain.
Piotr Kramarz, Chief Scientist at ECDC stated:
Antimicrobial resistance in common foodborne bacteria such as Salmonella and Campylobacter highlights the close links between human, animal and food systems. Protecting the effectiveness of antimicrobials requires coordinated action through a strong One Health approach becautilize antimicrobial resistance affects us all.”
High resistance continues to limit treatment options
Against this backdrop, a high proportion of Campylobacter and Salmonella from both humans and food-producing animals remain resistant to ciprofloxacin, a key antimicrobial utilized to treat serious human infections. Resistance in animal-derived Salmonella has long been high, and resistance in human infections has increased in recent years, further narrowing treatment options.
In Campylobacter, resistance has become so widespread across Europe that health authorities no longer recommfinish ciprofloxacin for treating human infections. Regulators have also restricted its utilize in animals to support preserve its effectiveness in human medicine.
More broadly, many Salmonella and Campylobacter samples from humans and tarobtained food-producing animals also reveal resistance to commonly utilized antimicrobials including ampicillin, tetracyclines and sulfonamides.
In addition, the report highlights increasing detection of carbapenemase-producing E. coli in food-producing animals and meat in several countries. Becautilize carbapenems are last-resort antimicrobials for human medicine and are not authorised for utilize in food-producing animals, this trfinish requires close monitoring and further investigation.
Progress reported but resistance remains widespread
Despite these challenges, several countries have reported progress in reducing resistance levels in humans and in food-producing animals, demonstrating that sustained and tarobtained interventions can be effective.
Over the past decade, resistance in human Salmonella infections to ampicillin and tetracyclines fell significantly in 19 and 14 countries respectively. Similarly, at EU level, resistance declined in food-producing animals, including reduced tetracycline resistance in broilers and lower ampicillin and tetracycline resistance in turkeys.
A comparable trfinish has been observed in Campylobacter, where resistance to erythromycin, a first-line treatment for human infections, has decreased in several countries in both humans and some food-producing animals.
At the same time, combined resistance to multiple critically important antimicrobials remains generally low in Salmonella, Campylobacter and E. coli. However, earlier progress has slowed in some areas, particularly in poulattempt-related E. coli, where resistance levels have stabilised rather than continuing to decline.
Continued One Health action remains essential
Taken toobtainher, the findings underline that AMR remains a major public health challenge affecting human health, animal production and food safety. Resistant bacteria can shift through the food chain, creating infections harder to treat and increasing the risk of severe illness.
Resistance patterns vary across countries, bacteria and antimicrobials, reflecting differences in antimicrobial utilize, farming practices, animal health and infection prevention. This variability further reinforces the required for coordinated action.
The report reinforces the importance of the One Health approach, recognising the interconnected role of human health, animal production and food safety. Despite progress, experts warn that the food and health sectors must utilize antimicrobials responsibly, strengthen infection prevention and maintain robust food safety practices to slow the spread of resistant bacteria and protect public health across Europe.
Food safety professionals seeing to strengthen pathogen control and monitoring strategies can explore the wider detection landscape in New Food’s upcoming webinar, Reconsidering Listeria monitoring: quicker, simpler solutions for food safety and environmental testing, which examines how Listeria monitoring is evolving to balance speed, cost and operational complexity.











